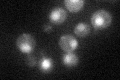
YKR079C
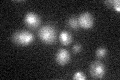
YKR079C

View description
tRNA 3'-end processing endonuclease tRNase Z; also localized to mitochondria and interacts genetically with Rex2 exonuclease; homolog of the human candidate prostate cancer susceptibility gene ELAC2
Localization:
Intensity:
Fold change:
Significance:
-
C’ GFP library in SD
nucleus33.31 -
N' NOP1pr-GFP in SD

N/A0 -
N' TEF2pr-mCherry in SD

N/A0 -
N' NATIVEpr-GFP in SD

N/A0 -
N' TEF2pr-VC and Cyto-VN in SD

N/A0 -
C’ GFP library in SD+DTT

nucleus30.110.9No -
C’ GFP library in SD+H2O2

nucleus28.690.86No -
C’ GFP library in Starvation Media
nucleus27.090.81No -
C’ GFP library on the background of Pup2-DaMP

nucleus -
C’ GFP library on the background of CCT mutant

nucleus30.5180.915953No
